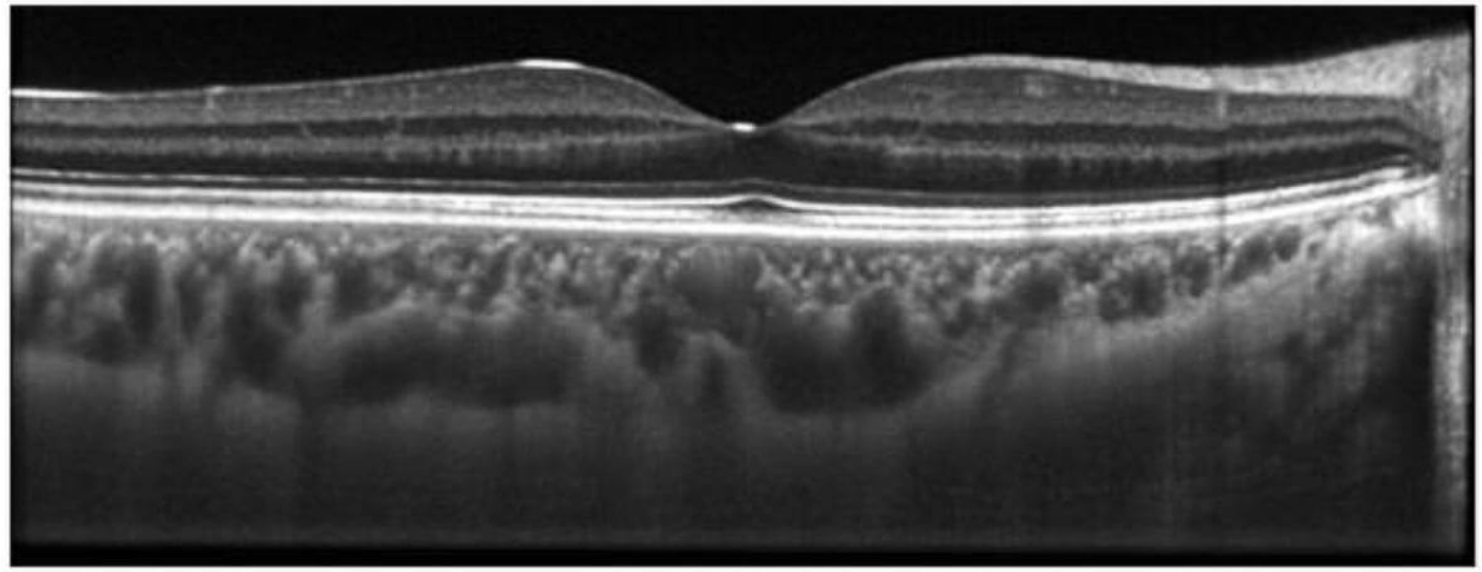
image.png image.png

EXALOS 臺式SLED光源
產(chǎn)品型號:EBS
所屬品牌:EXALOS
產(chǎn)品簡介:深圳因諾爾科技有限公司代理瑞士EXALOS臺式SLED寬帶光源根據(jù)所選的SLED模塊,光輸出可以用單模光纖實現(xiàn),也可以用保偏光纖實現(xiàn)。
EXALOS為研究、開發(fā)、生產(chǎn)和測試環(huán)境提供各種形狀的高度可定制的臺式儀器。我們的臺式儀器最多可配置八個SLED,用于超寬帶光源。
我們的寬帶光源可以為每個SLED具有單獨的光學(xué)輸出,也可以配置為具有一個公共輸出,其中單個SLED的光譜被組合在一起。在長波長范圍內(nèi),EXALOS可以提供1270至1620nm的超寬帶350nm光源,具有超過40mW的光輸出功率。
在短波長范圍內(nèi),EXALOS可以提供750至920nm的超寬帶170nm光源。
EBS30和EBS40系列通過電氣模擬和數(shù)字控制信號以及高達50 Hz的調(diào)制功能提供遠程控制。可選地,可以使用光纖去極化器來實現(xiàn)低偏振度(DOP)。此外,可以實現(xiàn)通過定制的光學(xué)帶通濾波器的光譜整形。
特征 Turn-key系統(tǒng) 超大光學(xué)帶寬;極短相干長度 通過模擬輸入電壓進行遠程電源控制 高光輸出功率 調(diào)制頻率高達50 Hz 低偏振度–可選 | 應(yīng)用 超高分辨率光學(xué)相干層析成像 生物醫(yī)學(xué)成像 多通道光纖布拉格光柵詢問 無源元件測試 光譜學(xué) 光纖傳感器 |
EBS是為超高分辨率光學(xué)相干層析成像而設(shè)計的。

用840nm寬帶SLED EXS210022和高分辨率光譜儀記錄的人類視網(wǎng)膜黃斑孔的3D OCT橫截面(由維也納醫(yī)科大學(xué)生物醫(yī)學(xué)工程與物理中心Rainer a.Leitgeb教授提供)。
技術(shù)指標(biāo)
型號 | 波長(nm) | 3dB帶寬(nm) | 10dB帶寬(nm) | 輸出功率(mW) | 相干長度(um HWHM) |
EBS300011-02 | 405 | 3 | 6 | 0.5 | 21 |
EBS300035-02 | 650 | 6 | 12 | 3 | 30 |
EBS400010-02 | 830 | 160 | 190 | 9 | 2.4 |
EBS300080-02 | 845 | 140 | 160 | 9 | 2.9 |
EBS300002-03 | 865 | 105 | 125 | 9 | 4.1 |
EBS300033-03 | 1030 | 180 | 200 | 5 | 3.3 |
EBS400033-02 | 1040 | 175 | 200 | 15 | 3.6 |
EBS300034-04 | 1070 | 100 | 120 | 20 | 6.5 |
EBS300059-02 | 1270 | 140 | 170 | 20 | 6 |
EBS300045-02 | 1280 | 145 | 185 | 15 | 6 |
EBS300040-02 | 1315 | 120 | 150 | 25 | 8 |
EBS300047-03 | 1325 | 100 | 150 | 20 | 9.1 |
EBS300058-02 | 1450 | 320 | 380 | 7 | 3.3 |
EBS400005-02 | 1460 | 320 | 360 | 40 | 3.1 |
EBS300006-03 | 1570 | 110 | 140 | 20 | 12 |
需要更多詳細信息,請聯(lián)系深圳因諾爾科技有限公司銷售人員。
深圳因諾爾科技有限公司
手機:18676666603
固話:0755-23771707
郵箱:sales@innoall.com





